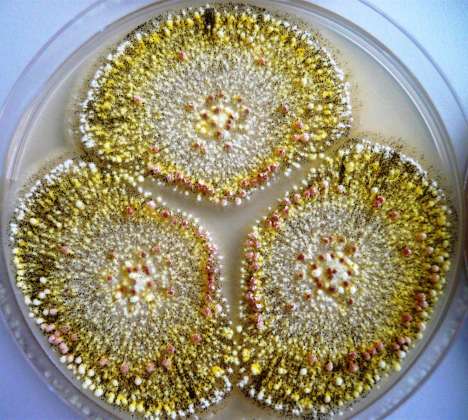
【养殖技术】霉菌毒素对母猪的危害竟如此之大？

什么是霉菌?
霉菌毒素是某些霉菌产生的有毒二次代谢产物,普遍存在于饲料原料中。霉菌毒素对猪群的危害也众所周知,降低了猪群的抵抗力,导致严重的免疫功能降低、*猪种**繁殖障碍、生长缓慢、抗生素治疗无效等现象。而母猪的正常发情和适时配种决定了猪场经营的成败。因此,充分认识霉菌毒素对母猪猪的危害,制订和实施其行之有效的防制措施,针对促进养猪业的健康发展、实现养殖效益的最大化具有重要的现实意义。

霉菌对母猪的危害:
(1)怀孕母猪:表现为死胎、木乃伊、流产或新生仔猪死亡率上升,以及产后发情不正常;
(2)青年母猪:饲料中含的玉米赤霉烯酮,即可引起青年母猪阴门红肿,子宫体积和重量增加,表现发情或临产症状;
(3)哺乳期母猪:表现为逐渐的拒食,表现持续发情或发情周期延长,影响哺乳期乳猪成活率;
(4)当饲料中霉菌毒素含量过多时,母猪会出现直肠和阴道脱出的现象。

霉菌毒素临床症状
机型中毒表现为大量猪发病,食欲降落
●发病严重,病死率高
●妊娠母猪流产、产死胎
●母猪发情不正常、假发情、返情率高
●母猪产死胎和弱仔的比例增加
●母猪产仔数明显降低,泌乳量减少
●有的母猪子宫脱出
人们通常认为,饲料稍微有点霉变应该没什么关系,不会引起中毒,从而放松了警惕。有些猪场认为,添加霉菌毒素处理剂增加饲料成本,所以常常是时加时不加,小猪饲料加,大猪饲料就不加,有的甚至母猪饲料都不加。
殊不知有时大猪的涨气、胃溃疡等突然死亡就是霉菌毒素造成的。长期添加霉菌毒素处理剂可降低动物的发病率和死亡率,而且还有吸附肠道毒素、控制和减少腹泻,提高饲料报酬,是养殖增效的好途径!
如何预防霉菌毒素?
1.控制好饲料原料的含水量。玉米、稻谷、高梁含水量控制在14%以内,豆粕、麸类、次粉含水量控制在13%以内,鱼粉、肉粉、骨粉含水量在12%以内。
2. 控制好原料与饲料的贮存条件,尤其要控制好仓库的温度、湿度,仓库要防漏。要求通风良好,原料与饲料不可直接接触地面或墙壁,减少存放时间,避免堆放于阴暗潮湿的地方。
3. 加强原料品质的管理,缩短原料储存时间,严格按照"先进先出"的原则使用,并及时清理被污染的原料。
4. 原料库应定期进行薰蒸消毒。
5. 严格控制饲料加工过程中的水分,配合饲料南方含水量不大于12.5%,北方含水量不大于14%;浓缩料南方含水量不大于10%,北方含水量不大于12%.
6. 添加防霉剂和霉菌毒素吸附剂。原料与饲料尤其在春夏、夏秋季节添加防霉剂和霉菌毒素吸附剂。
